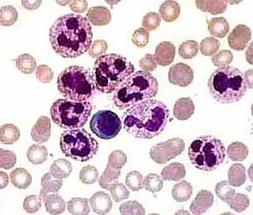
нейтрофилы в крови понижены

Нейтрофилы являются самой большой группой лейкоцитов, которые обеспечивают защиту организма от множества инфекций. Данный вид лейкоцитов формируется в костном мозге. Проникая в ткани человеческого организма, нейтрофилы уничтожают патогенные и чужеродные микроорганизмы методом их фагоцитоза.
Нейтрофилы являются самой большой группой лейкоцитов, которые обеспечивают защиту организма от множества инфекций. Данный вид лейкоцитов формируется в костном мозге. Проникая в ткани человеческого организма, нейтрофилы уничтожают патогенные и чужеродные микроорганизмы методом их фагоцитоза.
Состояние, когда в крови нейтрофилы понижены, называется в медицине нейтропенией. Обычно это говорит о быстром разрушением этих клеток, органическим или функциональным нарушением кроветворения в костном мозге, истощением организма после длительно протекающих заболеваний.
О нейтропении говорят, если содержание нейтрофилов у взрослого человека ниже нормы и составляет от 1,6Х10⁹ и меньше. Снижение может быть истинным, если изменяется их количество в крови, и относительным, если уменьшается их процент по отношению к остальным лейкоцитом.
В этой статье мы рассмотрим, почему нейтрофилы понижены у взрослых, и что это значит, а также как повысить эту группу лейкоцитов в крови.
Какая норма нейтрофилов?
Показатель нейтрофилов в крови напрямую зависит от возраста человека. У детей до одного года нейтрофилы составляют от 30 % до 50 % от лейкоцитов, когда ребенок растет, у него начинает увеличиваться уровень нейтрофилов, в семь лет количество должно быть от 35% до 55%.
У взрослых норма может колебаться от 45% до 70%. В случаи отклонения от нормы, когда показатель ниже, можно говорить о пониженном уровне нейтрофилов.
Степени тяжести
Степени нейтропении у взрослых:
- Легкая нейтропения — от 1 до 1.5*109/л.
- Умеренная нейтропения — от 0.5 до 1*109/л.
- Тяжелая нейтропения — от 0 до 0.5*109/л.
Виды нейтропении
В медицине выделяют три вида нейтропении:
- Врожденная;
- Приобретенная;
- Неизвестного происхождения.
Нейтрофилы могут периодически снижаться, затем приходить в норму. В этом случае речь идет о цикличности нейтропении. Она может быть самостоятельным заболеванием или развиваться при определенных заболеваниях. Врожденная доброкачественная форма передается по наследству и никак клинически не проявляется.

Классификация
Современная медицина выделяет два вида нейтрофилов:
- Палочкоядерные — незрелые, с не до конца сформированным палочкообразным ядром;
- Сегментоядерные — имеют сформированное ядро, имеющее чёткую структуру.
Нахождение в крови нейтрофилов, а также таких клеток, как моноциты и лимфоциты, непродолжительно: оно варьируется от 2 до 3 часов. Затем происходит их транспортировка в ткани, где они пробудут от 3 часов до пары суток. Точное время их жизни во многом зависит от характера и истинной причины воспалительного процесса.
Причины пониженных нейтрофилоф
Что это значит? В случае если анализ крови показывает что нейтрофилы понижены, необходимо сразу начинать активное устранение причины.
Такими факторами являются:
- длительно протекающим воспалительным процессом в организме;
- тяжелой вирусной инфекцией (корь, краснуха, ВИЧ);
- генерализованной грибковой инфекцией;
- паразитарными агентами (токсоплазмоз, малярия);
- наследственной патологией (синдром Костмана);
- радиоактивным облучением;
- химиотерапией при лечении онкологии;
- гельминтами, а точнее, выделяемыми ими токсинами;
- аллергией (нейтрофилы понижены после анафилаксии);
- действием экзогенных токсинов (некоторые яды и химические вещества);
- приемом некоторых лекарств (хлорамфеникол, зидовудин, сульфаниламидные антибиотики);
- поражением костного мозга опухолевым процессом, в том числе и метастатическим.
Однако судить о заболевании только на основании одного анализа крови не очень-то достоверно. Для того, чтобы поставить правильный диагноз, необходимо не только оценить число нейтрофилов в крови, но и другие важные показатели. Именно поэтому многие люди считают, что для постановки правильного диагноза стоит только сдать кровь. Но показатели крови — косвенные. К тому же только при наличии этого анализа и без осмотра больного трудно определить, чем же именно заболел человек — гельминтами или краснухой.
Сегментоядерные нейтрофилы понижены, а лимфоциты повышены
Если сегментоядерные нейтрофилы понижены, а лимфоциты повышены, причинами такого состояния могут быть:
- вирусные заболевания;
- ВИЧ;
- туберкулез;
- проблемы со щитовидной железой;
- лимфолейкоз;
- лимфосаркома.
Таким образом, можно сделать вывод: если повышены лимфоциты и понижены нейтрофилы, то в организме присутствует очаг инфекции, скорее всего вирусной. Однако результаты анализа крови нужно сопоставлять с клинической картиной.
Если какие-либо признаки заболеваний отсутствуют, возможно, речь идет о носительстве вируса. При понижении уровня гранулоцитов с одновременным повышением лимфоцитов требуется полное обследование, поскольку не исключены такие опасные патологии, как гепатиты, ВИЧ.
Лечение
Стоит понимать, что прямых средств, позволяющих повысить нейтрофилы у взрослых нет. Для них действуют те же условия, что и при пониженных лейкоцитах в целом. При обнаружении выраженного отклонения от нормы доктор должен предпринять меры по скорейшему устранению причины патологии.
Если нейтрофилы у взрослых понижены из-за принимаемой лекарственной терапии, то врач должен произвести коррекцию схемы лечения, вплоть до замены или полной отмены лекарств, подавляющих выработку нейтрофилов.
В некоторых случаях причиной является дисбаланс питательных веществ, и тогда задача стоит в коррекции фона витаминов группы B (в частности B9 и B12) при помощи препаратов или назначения диеты. Как правило, после устранения провоцирующего фактора показатель нейтрофилов самостоятельно возвращается к норме за 1-2 недели.


Автор сначала указывает на содержание с/я нейтрофилов в %%, а показатели нейтрофилопении дает в размерах 0-1.5*10/9. Данные анализа крови обычно выражены в %%. А как перейти от %% в указанные величины, чтобы оценить уровень н/пении?
К какому врачу обращаться, если нейтрофилы понижены, а лимфоциты повышены? Возраст- 58 лет.
Ксения,добрый день! У меня история с анализами точно такая! Возраст -60 лет.К врачам обращалась к нескольким терапевтам.Все в один голос говорят, что ничего серьезного не происходит,но я начитавшись и получив кучу информации из всех источников, на самом деле очень переживаю, так как состояние здоровья,скажем, оставляет желать лучшего.Если вы что- нибудь узнали напиши мне,плиз.А я буду вам сообщать все новости, я конечно буду узнавать и дальше.
К гематологу!
К гематологу!
Здравствуйте. Прошло уже 5лет.вы узнали свою болезнь? Как здоровье на сегодня? Буду рада ответу.
Ксения, добрый день!
В вашем случае идет воспалительный процесс в организме (простуда/хронические заболевания типа хрон тонзиллита). Если обычный терапевт разводит руками, то сходите к ЛОРу или к иммунологу, он назначит полный анализ на вирусы, возможно какой-то вирус у вас сидит.
а еще хорошо бы посетить эндокринолога. У меня тоже такие же данные — с печенью проблема. Проверьте на УЗИ
Люди, обращайтесь не к терапевтам, а к Гематологам
Обращалась я к гематологу. Сделали пункцию, в заключении : заболевания крови нет!
А анализ крови опять показывает нейтрофилы понижены, а лимфоциты повышены.
Ну я бы на это и внимание не обращала, если бы со здоровьем было всё в порядке.
Но ведь я очень плохо себя чувствую, а теперь ещё и вся кожа покрылась болячками,
и сильный зуд мучает. Врачи молчат….Только делают предположения: может снижен
иммунитет, может сбой в эндокринной системе. У меня узлы на щитовидке, но гормоны в норме
Это ВЭБ, возможно.
СДАЙТЕ КРОВЬ НА ТОКСАКОРОЗ,ЭТО ОЧЕНЬ ВАЖНО,МЫ С ТАКИМ СТОЛКНУЛИСЬ
А терапевт направляет к гематологу..
Также проблема.но болят суставы.
влияет ли гормональный препарат анастрозол на количество нейтрофилов и лимфоцитов?
Добрый день ,Марина! Увидела Ваш комментарий по поводу болей в суставах.У меня еще и в мышцах боли! А суставы болят все-от кончиков пальцев на руках до кончиков пальцев на ногах(((
Нейтрофилы-49,4% при норме 50%,лимфоциты-42,8% при норме 40%.Мне 46 лет,год назад удалили матку и яичники(миоматозные узлы и кисты)
С марта у Вас что-нибудь прояснилось?
Здравствуйте. всем.
Мне 72 года. Нейтрофилы 31, Лимфоциты 56.
Врач говорит, что ничего страшного.
А у меня всё болит, и спина и грудь и всё внутри
Вот и обращайся к ним за помощью
Видно, нам старикам не стоит и рассчитывать на помощь,
если уж молодых не хотят лечить.
Кто, что-нибудь может посоветовать?
Спасибо.
Добрый день! Попробуйте задать вопрос докторам Мясникову и Агапкину по этой теме.
Обращаться надо не к Мясникову и не к Агапкину- а к врачам Гематологам.
Повышение лимфоцитов, говорит о застое лимфатической системы. Лимфа это жидкость, которая собирает и выводит все продукты жизнедеятельности клеток. Когда лимфа стоит, стоят и отходы, а затем они начинают бродить. Чтобы разогнать лимфу хорошо подходят прогулки, контрастный душ, парить ноги, и просто побольше движения.
фигня. Я занимаюсь бегом. Нейтрофилы понижены, лейкоциты повышены. Не болею. И самочувствие отличное.
Марина, а сколько вам лет? если, конечно, не секрет
я думаю причина в витамине В, вернее отсутствии нормы в организме. Пропила как то витаминфы. и стало норма, а до этого пожизненно была не норма. сейчас прошло время и анализ снова нейрофилы понижены, лимфоциты повышены. уверена дело в витаминах группы В, В9 и В12
Добрый день у меня таже история нейтрофилы понижены лемфоциты повышены Мой совет анализ крови общий, биохимический включая все особенно мочевую кислоту и креатинин мой возраст 60 лет выяснилась проблема с почками, хотя никогда не болели
Мне 65. нейтрофилы понижены -40,6 а лимфоциты повышены-41,0 Был на приеме у инфекциониста. обнаружили -ВЭБ вирус Эшпейна Барра. выписали Противовирусные, Вопрос так как же пронимать Гроприносин если нейтрофилы и так понижены??? А со здоровьем не очень то бок болит то спина проблемы с ЖКТ. а терапевт ни чего не находит. а когда говоришь про вирус Он просто заявляет что от этого вируса ни чего болеть не может!!!
Здравствуйте. Прошло уже 5лет.вы узнали свою болезнь? Как здоровье на сегодня? Буду рада ответу.